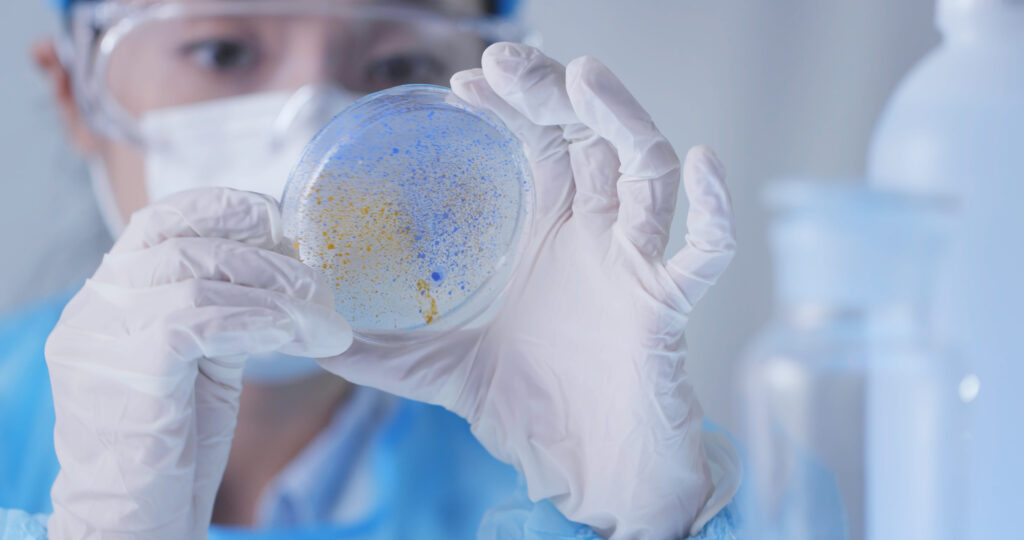

UnitedHealth Group Incorporated (NYSE:UNH) stands as one of the largest and most influential healthcare companies in the world, serving millions of individuals through a comprehensive network of insurance, medical services, data analytics, and pharmacy care operations. Headquartered in Minnetonka, Minnesota, UnitedHealth Group operates through two primary platforms — UnitedHealthcare and Optum — each designed to work in synergy to improve healthcare access, affordability, and outcomes across the United States and globally. Established in 1977, the company has grown from a regional health insurer into a global healthcare powerhouse with an integrated approach that bridges insurance coverage, clinical services, and health technology. Its mission is to help people live healthier lives while making the health system work better for everyone, combining financial strength with healthcare expertise to lead one of the most complex and regulated industries in the world.
UnitedHealthcare, the company’s insurance arm, provides health benefit plans and related services to individuals, employers, and government programs such as Medicare and Medicaid. It is widely recognized as the largest single health carrier in the United States, offering products that range from traditional health coverage to specialty benefits like dental, vision, and pharmacy care. The division also plays a major role in public healthcare delivery through Medicare Advantage plans, Medicaid contracts, and coverage for children and low-income families. Its customer-centric strategy is rooted in scale and innovation, helping reduce costs while maintaining access to quality care across an expanding national network of hospitals, clinics, and physicians.
Complementing this is Optum, UnitedHealth Group’s technology-driven health services business, which focuses on care delivery, data analytics, and pharmacy benefit management. Optum operates through three segments — Optum Health, Optum Insight, and Optum Rx — each contributing unique capabilities to the company’s ecosystem. Optum Health delivers integrated care and wellness programs to millions of patients, Optum Insight provides data analytics and information technology services to healthcare providers and payers, and Optum Rx manages pharmacy benefits with a focus on lowering drug costs and improving patient adherence. Together, these businesses leverage data and advanced analytics to address inefficiencies in the healthcare system and support evidence-based care decisions.
UnitedHealth Group’s success has been built on its scale, operational efficiency, and ability to anticipate changes in the healthcare landscape. Over the decades, it has expanded both organically and through acquisitions, cementing its leadership in managed care and health technology. The company’s integrated model allows it to balance risk across multiple revenue streams, making it less vulnerable to market fluctuations compared to traditional insurers. With a customer base that spans individuals, employers, state governments, and federal agencies, UnitedHealth Group plays a central role in shaping healthcare policy, cost structures, and innovation in care delivery.
As of 2025, UnitedHealth Group employs more than 400,000 people and serves customers in over 130 countries. Its financial stability and diversified portfolio have made it a mainstay in both the S&P 500 and the Dow Jones Industrial Average. The company consistently ranks among the Fortune 5 and has earned recognition for its innovation in digital health solutions, predictive analytics, and value-based care models. With its vast resources and technological capabilities, UnitedHealth Group continues to invest in programs that address public health challenges, preventive medicine, and healthcare equity, aiming to reduce disparities in access and outcomes across communities.
Despite operating in a heavily regulated environment, UnitedHealth Group has maintained a reputation for resilience and adaptability. Its long-term strategy centers on integrating data, technology, and human expertise to transform healthcare delivery and create sustainable systems that serve patients and providers alike. This commitment to innovation and patient-centered care has positioned the company not only as a healthcare provider but also as a global thought leader in advancing modern medical solutions. With decades of experience, extensive partnerships, and unmatched scale, UnitedHealth Group remains at the forefront of redefining how healthcare is delivered, financed, and experienced in the modern era.
UnitedHealth Group: A Healthcare Titan Showing Early Signs of Structural Stress
UnitedHealth Group Incorporated (NYSE: UNH) has long been the gold standard of consistency in the American healthcare sector, renowned for its dominant market share, strong earnings power, and deep integration across insurance, pharmacy benefits, and medical services. Yet beneath that reputation of reliability lies growing tension. The company’s latest financial results, management challenges, and regulatory headwinds reveal a system under strain — one that could reshape investor sentiment around what was once seen as an invincible blue-chip healthcare stock.
CHECK THIS OUT: Tiziana (TLSA) Surges 143% in 2025 and Immuneering (IMRX) Reports 86% 9-Month Survival in Pancreatic Cancer.
Earnings Miss Highlights Margin Compression and Operational Headwinds
In its most recent quarterly earnings release, UnitedHealth reported earnings of $4.08 per share, missing Wall Street estimates of $4.45. Revenue rose 12.9% year-over-year to $111.62 billion, but the growth masked a deeper problem: higher costs are eating into margins. The company’s net margin slipped to 5.04%, while its return on equity fell to 23.32% — signs that rising medical utilization, cost inflation, and reimbursement pressure are beginning to erode profitability.
This is particularly concerning because UnitedHealth has historically been valued for its predictable earnings trajectory. Missing analyst targets, even by a modest margin, calls into question the company’s visibility into near-term cost trends and its ability to manage expense pressures across multiple business units simultaneously.
Medicare Advantage: From Profit Engine to Regulatory Minefield
For over a decade, UnitedHealth’s Medicare Advantage (MA) segment has been its most profitable business line, buoyed by scale and efficient claims management. But that moat is shrinking. Recent government scrutiny over risk-adjustment coding practices, combined with higher utilization among seniors, is putting substantial pressure on MA profitability.
Regulators are now questioning how insurers like UnitedHealth report patient diagnoses to maximize reimbursements, and the Department of Justice’s ongoing investigations could lead to stricter oversight or even financial penalties. These risks are not hypothetical — they threaten to reduce margins across an entire division that accounts for a large portion of UnitedHealth’s earnings base. The same factors prompted the company earlier this year to withdraw its full-year guidance, signaling uncertainty around future performance.
Complex Business Model, Rising Integration Risk
UnitedHealth’s size, once its greatest strength, now represents a potential weakness. The company’s four main divisions — UnitedHealthcare, Optum Health, Optum Insight, and Optum Rx — form a vast, vertically integrated ecosystem spanning insurance, care delivery, pharmacy management, and data analytics.
While this model provides diversification, it also amplifies operational complexity. The company is now contending with rising administrative costs, tighter compliance requirements, and execution challenges as it attempts to maintain consistency across hundreds of interdependent systems. Reports of inefficiencies within Optum and concerns about cybersecurity resilience have further eroded investor confidence. Integration across so many regulatory environments is proving increasingly expensive, especially as the U.S. government tightens data and privacy standards across healthcare systems.
Institutional Ownership: Confidence or Complacency?
Institutional investors continue to own roughly 87.86% of UnitedHealth’s stock — a number that, while impressive, also heightens the potential for volatility if large funds decide to rotate out. Cardano Risk Management B.V. recently increased its holdings by 2.4%, bringing its total to 263,367 shares valued at $82.16 million. This might appear bullish on the surface, but it also represents only a marginal portfolio allocation, suggesting tempered conviction.
Meanwhile, major holders such as Vanguard Group Inc. and Wellington Management Group LLP have boosted their positions, yet this institutional loyalty is increasingly being tested by declining earnings predictability and downgrades from key analysts. When consensus shifts among large funds, the selling pressure can accelerate rapidly — especially in a stock with such concentrated ownership.
Dividend Stability Masks Deeper Cash Flow Concerns
UnitedHealth continues to return capital to shareholders through a quarterly dividend of $2.21 per share, translating to an annualized yield of 2.4%. Its payout ratio of 38.3% appears healthy for now, supported by robust free cash flow. However, investors should be cautious: dividend stability can give a false sense of security when cost inflation and regulatory expenses are rising faster than earnings.
The company’s debt-to-equity ratio of 0.73 and current ratio of 0.85 suggest moderate financial leverage, but not a wide safety buffer. Should compliance penalties, Medicare clawbacks, or further medical-cost surges materialize, cash conservation could quickly take precedence over payout expansion — especially if the company’s earnings trajectory weakens further.
Analyst Sentiment Turns Mixed as Valuation Premium Erodes
Market optimism around UnitedHealth is cooling. Once considered a must-own defensive stock, it now faces a divided analyst community. Out of 27 analysts tracked, 16 rate UNH as a Buy, seven as Hold, and four as Sell. Both Weiss Ratings and Baird R W recently downgraded the stock to Sell and Strong Sell, citing declining visibility, regulatory exposure, and shrinking margin flexibility.
Despite a few bullish upgrades from Mizuho, Bank of America, and Wells Fargo, the average price target sits at $383.09, just marginally above current levels near $367. That limited upside reflects growing skepticism that UnitedHealth can sustain premium multiples amid structural pressure on earnings.
Valuation Risks and the End of the “Defensive” Narrative
UnitedHealth currently trades at a P/E ratio of 15.9 and a PEG ratio of 2.39, which may seem reasonable until compared with industry peers facing lower regulatory risk and similar growth prospects. The company’s beta of 0.47 once made it a low-volatility anchor for institutional portfolios, but recent price action tells a different story. Shares have swung from a 52-week high of $630.73 to a low of $234.60, reflecting not stability, but increasing investor anxiety.
The erosion of its “defensive stock” status could be one of the most underappreciated risks moving forward. As healthcare inflation rises and federal reimbursement models shift, the pricing power that once protected UnitedHealth’s earnings could diminish faster than anticipated.
Conclusion: A Blue-Chip Under Pressure
UnitedHealth Group remains a dominant force in U.S. healthcare, but the fundamental narrative is shifting. Rising utilization costs, regulatory scrutiny, operational inefficiencies, and an uncertain macro backdrop are collectively eroding the company’s growth premium. While long-term investors may still view UNH as a cornerstone holding, short- to medium-term downside risks appear significant.
The combination of lower earnings visibility, softening analyst sentiment, and a complex operating structure makes UnitedHealth increasingly vulnerable to valuation compression. In an era of heightened political and regulatory focus on healthcare profits, the company’s immense scale — once its greatest strength — may now become the very factor that limits its flexibility. For investors, caution rather than conviction may be the prudent stance as UnitedHealth navigates one of the most uncertain periods in its recent history.
READ ALSO: Saudi Arabia Wants CEL-SCI (CVM)’s Multikine Now! and Aligos Therapeutics (ALGS) Doubles Cash to $122.9M.